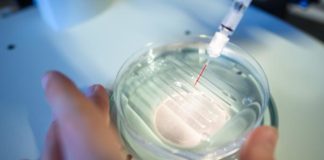

Welcome!Log into your account
© Faina Idea 2019 - Использование материалов разрешается при условии размешения ссылки ( онлайн-издания гиперссылки ) на fainaidea.com.